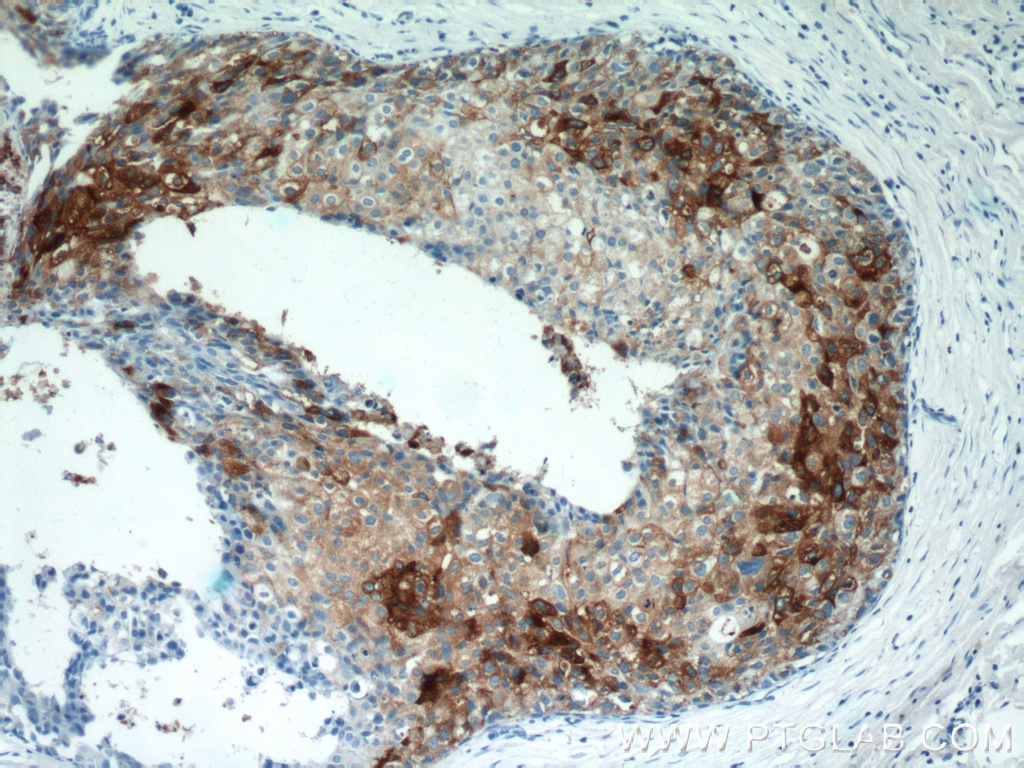

验证数据展示
经过测试的应用
| Positive WB detected in | human plasma |
| Positive IHC detected in | human tonsillitis tissue, human breast cancer tissue, human liver cancer tissue Note: suggested antigen retrieval with TE buffer pH 9.0; (*) Alternatively, antigen retrieval may be performed with citrate buffer pH 6.0 |
| Positive IF-P detected in | human liver tissue, HeLa cells |
| Positive IF/ICC detected in | HeLa cells |
推荐稀释比
| 应用 | 推荐稀释比 |
|---|---|
| Western Blot (WB) | WB : 1:2000-1:12000 |
| Immunohistochemistry (IHC) | IHC : 1:300-1:1200 |
| Immunofluorescence (IF)-P | IF-P : 1:50-1:500 |
| Immunofluorescence (IF)/ICC | IF/ICC : 1:50-1:500 |
| It is recommended that this reagent should be titrated in each testing system to obtain optimal results. | |
| Sample-dependent, Check data in validation data gallery. | |
产品信息
12289-1-AP targets Clusterin in WB, IHC, IF/ICC, IF-P, CoIP, ELISA applications and shows reactivity with human samples.
| 经测试应用 | WB, IHC, IF/ICC, IF-P, ELISA Application Description |
| 文献引用应用 | WB, IHC, IF, CoIP |
| 经测试反应性 | human |
| 文献引用反应性 | human, rabbit |
| 免疫原 |
CatNo: Ag2889 Product name: Recombinant human CLU protein Source: e coli.-derived, PGEX-4T Tag: GST Domain: 101-449 aa of BC010514 Sequence: VCNETMMALWEECKPCLKQTCMKFYARVCRSGSGLVGRQLEEFLNQSSPFYFWMNGDRIDSLLENDRQQTHMLDVMQDHFSRASSIIDELFQDRFFTREPQDTYHYLPFSLPHRRPHFFFPKSRIVRSLMPFSPYEPLNFHAMFQPFLEMIHEAQQAMDIHFHSPAFQHPPTEFIREGDDDRTVCREIRHNSTGCLRMKDQCDKCREILSVDCSTNNPSQAKLRRELDESLQVAERLTRKYNELLKSYQWKMLNTSSLLEQLNEQFNWVSRLANLTQGEDQYYLRVTTVASHTSDSDVPSGVTEVVVKLFDSDPITVTVPVEVSRKNPKFMETVAEKALQEYRKKHREE 种属同源性预测 |
| 宿主/亚型 | Rabbit / IgG |
| 抗体类别 | Polyclonal |
| 产品类型 | Antibody |
| 全称 | clusterin |
| 别名 | AAG4, Aging-associated gene 4 protein, Apo J, APOJ, Apo-J |
| 计算分子量 | 449 aa, 53 kDa |
| 观测分子量 | 37 kDa |
| GenBank蛋白编号 | BC010514 |
| 基因名称 | CLU |
| Gene ID (NCBI) | 1191 |
| RRID | AB_2083316 |
| 偶联类型 | Unconjugated |
| 形式 | Liquid |
| 纯化方式 | Antigen affinity purification |
| UNIPROT ID | P10909 |
| 储存缓冲液 | PBS with 0.02% sodium azide and 50% glycerol, pH 7.3. |
| 储存条件 | Store at -20°C. Stable for one year after shipment. Aliquoting is unnecessary for -20oC storage. |
背景介绍
Clusterin (Apolipoprotein J) is a 75-80 kDa heterodimeric glycoprotein produced by a wide array of tissues and found in most biologic fluids (PMID: 7648419; 11906815). It is encoded by one single gene and cleaved posttranslationally into α (34-36 kDa) and β (36-39 kDa) subunits prior to secretion from the cell. Many functions have been described for clusterin, including regulating apoptosis, transporting lipids, controlling cell interactions, regulating complement (PMID: 10694874).
实验方案
| Product Specific Protocols | |
|---|---|
| IF protocol for Clusterin antibody 12289-1-AP | Download protocol |
| IHC protocol for Clusterin antibody 12289-1-AP | Download protocol |
| WB protocol for Clusterin antibody 12289-1-AP | Download protocol |
| Standard Protocols | |
|---|---|
| Click here to view our Standard Protocols |
发表文章
| Species | Application | Title |
|---|---|---|
J Clin Invest Chromosomal 3q amplicon encodes essential regulators of secretory vesicles that drive secretory addiction in cancer | ||
Proc Natl Acad Sci U S A Addiction to Golgi-resident PI4P synthesis in chromosome 1q21.3-amplified lung adenocarcinoma cells. | ||
Sci Signal Platelets contribute to amyloid-β aggregation in cerebral vessels through integrin αIIbβ3-induced outside-in signaling and clusterin release. | ||
Front Cell Dev Biol Structural and Functional Characterization of Fibronectin in Extracellular Vesicles From Hepatocytes. | ||
Ecotoxicol Environ Saf Identification and functional analysis of senescence-associated secretory phenotype of premature senescent hepatocytes induced by hexavalent chromium. | ||
Food Chem Toxicol Clusterin overexpression as a potential neuroprotective response to the pathological effects of high fat dieting on the brain reward system. |